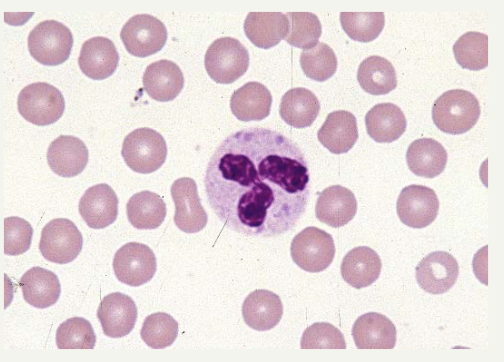

Sources of the multinucleated giant cells
Macrophages
Epithelioid Cell
Large, pale staining macrophages that have an ovoid nucleus and shape resembling epithelial cells
Condition

Johne’s Disease
Focal Inflammation
Single abnormality or inflamed are within a tissue
Morphology of eosinophils
Larger than neutrophils
Affinity of cytoplasmic granules to eosin (acid)
Lysosomal granules contain wide variety of catalytic enzymes similar to neutrophils
T/F: Fibrosis and neovascularization are features of subacute infection
False
Leukocytes
Normal inhabitants of the circulating blood
Total count of leukocytes in circulating blood modified by systemic response to inflammation
Each cell type has distinctive role
Each cell type enters into the inflammatory response in a definite sequence
Classification of inflammation by duration

Subacute Inflammation
Classification of inflammation based on exudate

Mucopurulent - Catarrhal
3 interconnected processes of phagocytosis
Recognition and attachment of the particle to be ingested
Engulfment with subsequent formation of phagocytic vacuole
Killing or degradation of the ingested material
Neutrophils
Crucial to inflammatory process
Constitute the first line of cellular defense
Develop in the bone marrow and the maturation process takes about two weeks
Functions of eosinophils
Modulate hypersensitivity reactions
Defend against helminthic infections
Phagocytic but less active phagocytes than neutrophils
Resolution of inflammation involves
Neutralization of chemical mediators
Return of normal vascular permeability
Cessation of leukocyte infiltration
Removal of edema fluid, leukocytes, foreign agents and necrotic debris
Hemorrhagic Inflammation
Hemorrhage is the main feature of this type of inflammation. Presence of an etiologic agent will indicate that the process is inflammatory rather than a primary circulatory disturbance
Sluggish motile but are responsive to chemotactic influences, they have a long life span (30-60days) and may proliferate at sites of inflammation
Macrophages
Epithelioid cells are specialized for
Extracellular secretion
Multinucleated Giant Cells
Formed by the coalescence of single macrophages
Lesion

Pleural Adhesions
Type of WBC

Lymphocytes and Plasma Cells
Time of onset of subacute inflammation
Depends on the nature of the inciting stimulus, may cover a considerable time span which can vary from a few days to a few weeks
Morphology of lymphocytes
Heterogeneous in size and morphology - smaller than neutrophils
Densely staining nucleus and scant amount of cytoplasm
Traditional division (T and B cells)
Functional division (Helper T, Cytotoxic T Cells)
Specific granules
Seconday granules - small, less dense and more numerous neutrophil granules
Inflammatory cells of peracute inflammation
Not usually numerous
Few leukocytes
Type of WBC
Neutrophil








































